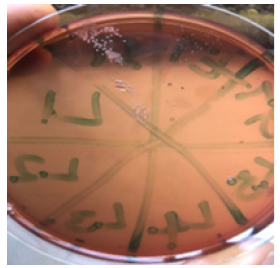

Research Article
Creative Commons, CC-BY
Bacteriological Assessment of Door Handles and Knobs at The Federal School of Medical Laboratory Technology Offices in Jos
*Corresponding author:Iyevhobu KO, Department of Public Health, National Open University of Nigeria, Uromi Community Study Centre, Uromi, Edo State, Nigeria.
Received:December 12, 2022; Published:December 19, 2022
DOI: 10.34297/AJBSR.2022.17.002387
Abstract
Microorganisms can be found everywhere, bacteria and fungi contaminate human body, our houses, workplaces, and our environment. Fortunately, among many billions of bacteria, only 1500 can be dangerous for our health, causing different disease such as pneumonia or skin infection. The human hand serves as a medium for the propagation of microorganisms from place to place, and from person to person. Although, it is nearly impossible for the hand to be free of microorganisms, as the presence of pathogenic bacteria may lead to chronic or acute illness. Every day, door handles are often hotspots for bacteria, public handles especially because of the frequent and inevitable use of most door handles, it can often be expected that bacteria are present. Many factors determine the suitability and population of bacteria. The material of the handle itself contributes to the growth of bacteria, with most door handles being constructed with stainless steel which are more suitable homes for bacteria. The material affects the time bacteria can survive on door handles; but more so, the temperature and humidity of the surrounding air, depending on these bacteria can thrive anywhere from a few hours to a few weeks. Human hands usually harbor microorganisms both as part of body normal flora as well as transient microbes contacted from the environment.
Keywords: Bacterial, Contamination, Door, Handles, Knobs
Introduction
Microorganisms can be found everywhere, bacteria and fungi contaminate human body, our houses, workplaces, and our environment. Fortunately, among many billions of bacteria, only 1500 can be dangerous for our health, causing different disease such as pneumonia or skin infection [1]. The human hand serves as a medium for the propagation of microorganisms from place to place, and from person to person. Although, it is nearly impossible for the hand to be free of microorganisms, as the presence of pathogenic bacteria may lead to chronic or acute illness [2]. Every day, door handles are often hotspots for bacteria, public handles especially because of the frequent and inevitable use of most door handles, it can often be expected that bacteria are present. Many factors determine the suitability and population of bacteria. The material of the handle itself contributes to the growth of bacteria, with most door handles being constructed with stainless steel which are more suitable homes for bacteria. The material affects the time bacteria can survive on door handles; but more so, the temperature and humidity of the surrounding air, depending on these bacteria can thrive anywhere from a few hours to a few weeks. Human hands usually harbor microorganisms both as part of body normal flora as well as transient microbes contacted from the environment [3].
The major source of the spread of community acquired infections are formites; such formites include door handles of convenience, showers toilet seats and faucets, sinks lockers, chairs, and tables especially those found in public places such as markets, banks, dormitories, schools, churches, public offices, hospitals, hotels, restaurants and rest rooms [4].The increasing incidence of epidemic outbreaks of certain diseases and its rate of spread from one community to the other has become a major public health concern [5]. Hand washing is fundamental cautionary measure to protect against the spread of diseases and is one of the primary practices to reduce the transfer of bacteria from person to person, or from person to food contact surfaces [6]. It is established that unwashed hands can transmit pathogens, especially fecal pathogens, to food product after visit to the toilet. Investigation of food borne illness showed that poor personal hygiene, primarily ineffective hand washing is an important contributor to foodborne illness [7]. Microbial contamination is a serious issue because it can lead to a wide range of health problem, hence the study of bacterial contamination of frequent hand contact on door handles/ knobs in the offices found in Federal School of Medical Laboratory Technology. It is on this note that the study is designed to investigate the presence or absence of bacteria in office door/knob handles in Federal School of Medical Laboratory Technology, Jos.
Material and Methods
This study was carried out in Federal School of Medical Laboratory Technology (science) Jos, Plateau State. A total of 30 office door handles/knobs were included in this study.
Sample Collection
Samples were collected using the swab-rinse method of the American Public Health Association as described by Reynolds, et al. [8]. Door handles were swabbed asceptically with sterile peptone water, it was then introduced into a bijou bottle containing sterile peptone water, shaken, and loosely capped. The bijou bottles were covered with cellophane and transported to Federal school of medical laboratory technology Jos laboratory. The rinse fluids were thawed and plated on Chocolate, MacConkey, and blood agar.
Sample Processing
Each collected specimen was processed to identify the bacteria
in the sample. The following processing techniques were employed.
a) Culture
b) Gram Staining
c) Motility
d) Biochemical Test
Culture Technique
Each door handle rinse fluid was aseptically inoculated into the media namely, Chocolate, MacConkey and Blood agar. The peptone water in which the door handle swabs were rinsed into, were gently shaken, and poured on the media plates and spread evenly over the entire surface of the media using a spreader (a sterile bent-glass rod). This was to allow for complete recovery of all organisms picked up in the swab. The plates were inoculated overnight at 37°C and examined (Figure1).
Macroscopy and Smear
Bacterial isolates were first differentiated by macroscopic examination of the colony. The colonies were differentiated based on size, colour, pigmentation, elevation surface texture, and margin, haemolysis on Blood, MacConkey, and Chocolate agar. A clean grease free slide was used, a smear by using a sterile wire loop to transfer an isolated colony from the culture plates to a grease free slide with a drop of normal saline, it was then spread an area the size of a dime and the slides were allowed to dry thoroughly (Figure2, Figure3).
Statistical Analysis
Statistical analysis was done using percentage positive.
Results
A total number of 30 samples collected from door handles/ knobs (front and back handles/ knobs) of offices were subjected to culturing, microscopy, and biochemical techniques to investigate the presence of contaminants and to establish the identity of the microorganism present. 8 door handles/knobs were sampled in the laboratory out of which 5 were positive, 5 door handles/ knobs were sampled in account department out of which 3 were positive, 5 door handles/knobs were sampled in the provost office out of which 2 were positive, 1 door handle/knob was sampled in bursary and it was positive, 6 door handles/knobs were sampled in the Administrative offices out of which 3 were positive and 5 door handles/knobs were sampled in other offices out of which 4 were positive Table 1. In the distribution of door handles/knobs samples assessed (30) about 18 where positive for bacteriology which accounts for 60% of the samples Table 1. In the prevalence of bacteria isolates in contaminated door handles/knobs, the organisms isolated are Staphylococcus aureus 13(43.3%), E. coli 7(23.3%), Klebsiella pneumoniae 6(20.0%) and Bacillus species 4(13.3%) (Table 1&2).
Discussion
Previous works and studies have shown that door handles and knobs are prone to contamination by bacteria, fungi and viruses which in turn serve as reservoirs for cross infection and recontamination of washed hands [4]. Some of these contaminants can be highly pathogenic and can be transferred from person to person or may result in autoinoculation [9]. In this study, door handles/knobs of offices in Federal School of Medical Laboratory Technology Jos were evaluated for bacterial contaminants. Result obtained Table 1 show that out of 30 samples assessed, 18 (60%) was contaminated. This figure was slightly lower than that obtained by Nworie, et al. [5] who recorded 86.7% positive cultures on door handles in public institutions and parks in Abuja metropolis. It could be due to constant cleaning and disinfection of the offices by cleaners. Though the percentage obtained (60%) was lower than that of Nworie, et al. [5], it’s slightly high for a place like Federal school of Medical Laboratory Technology Jos, that has sewage system designed to reduce incidence contamination. The results obtained in this study revealed a higher level of bacterial contaminants on door handles of offices and laboratories in which 60% of the analyzed door handles swab samples were contaminated with considerable number of pathogenic bacteria most of which were gram-positive bacteria and others, gram-negative bacteria. This observation could be due to the fact that most skin bacteria flora are gram positive and may have found their way onto the surface, through cross contamination, poor personal hygiene of the users or diseases spreading vectors such as cockroaches and files [10].This observation collaborates with that of Lynn, et al. [11] who reported the presence of pathogenic microorganisms on 70% of the selected door handles within secondary schools in Bokkos. Also, similar study by Nworie, et al. [5], reported 86.7% of door handle samples of selected public conveniences in Abuja Metropolis, were positive with pathogenic bacteria contamination.
This observation is similar study by Amala, et al. [12] observed (85%) bacterial contamination in offices and toilets doorknobs. This variation in the number of positive samples from one place to another is likely to be because of the differences in hygiene and sanitary conditions in the environment. Microbial contamination of doorknobs or handles are well of documented, and this could serve as vehicles for cross infections and re-contamination of washed hands [4,13,14]. Some of the contaminants can be highly pathogenic and can be transferred from one person to another or may result in auto- inoculation [9,15]. The result of this study showed that Staphylococcus aureus, Bacillus spp, Escherichia coli and Klebsiella spp, were the main bacterial isolates identified from the door handle samples. This observation is line with that of Salim, et al. [10] who reported to have isolated Staphylococcus aureus, Bacillus spp and Escherichia coli from selected door handles of public toilets in Federal University Dutse, Jigawa- State, Nigeria. Also study by Mensha, et al. [16] reported to have isolated Pseudomonas sp., Klebsiella Pneumonia, Neisseria sp., and Escherichia coli in selected door handles in a Southwestern University in Nigeria. The most frequently isolated bacterium was Staphylococcus aureus 13(43.3%) compared to other of its bacterial isolate counterpart. This could be since Staphylococcus spp are major components of the normal flora of the skin and nose, which probably explain its high prevalence as contaminant as it can easily be discharged by several human activities. This observation is in conformity with the finding of other researchers [5,17]. Staphylococcus aureus is the most important potential pathogen that cause boils, abscesses, wound infection, toxic shock syndrome and pimples
A high percentage prevalence of Bacillus spp (13.3%) observed in this study, could be explained by their spore forming ability which makes them able to resist harsh environmental conditions, withstand dry heat and certain chemical disinfectant for a considerable period. This observation is in line with report by Samy, et al. [18] The presence of gram-negative rods such as Escherichia coli and Klebsiella spp, isolates in this study indicates the possibility of the presence of faecal contamination on the door handles. This might be since most people go to toilet and end up contaminating their hands with faecal and urinal material and fail to wash their hand because they take the issue of hygiene with levity, they also lack the concept of hand washing as a simple means of stopping this spread of infectious agents. Gram negative sepsis and urinary tract infections are most caused by Escherichia coli and Klebsiella spp.
Conclusion
The presence of Staphylococcus aureus, Bacillus spp.,
Escherichia coli and Klebsiella spp., in the analyzed door handle
samples is an indication that public contact surfaces such as door
handles are often colonized by pathogenic microorganisms and may
serve as a potential source of infections. It is therefore a necessity
that personal hygiene be made a priority to help curb the public
health hazards that may be associated with these contaminated
door handles.
i. Regular cleaning of door handles of offices may reduce the
load of bacterial contamination.
ii. Hand sanitizers or spray disinfectants should be made
available in all offices, laboratories and toilets within Federal School
of Medical Laboratory Technology Jos
iii. Use of self-disinfecting technology on the door handles to
minimize the attachment of microbes or to delay the development
of biofilm.
iv. Use of the door handles made of a heavy metal such as
silver or copper to reduce the microbial load.
v. Further studies are recommended to validate the results
of the present study.
Conflict of Interest
The authors declare no conflicts of interest. The authors alone are responsible for the content and the writing of the paper.
Funding
This research did not receive any grant from funding agencies in the public, commercial, or not-for-profit sectors.
Authors’ Contributions
All authors participated in the entire process of the research.
Acknowledgements
The authors would like to thank all the Laboratory and technical staffs of Federal School of Medical Laboratory Technology Offices Jos for their excellent assistance and St Kenny Research Consult for providing medical writing support/editorial support in accordance with Good Publication Practice (GPP3) guidelines.
References
- Eltablawy SY, Elhinfnawi HN (2009) Microbial Contamination of some Computer Keyboards and Mice in National Center for Radiation Research and Technology. J World Appl Sci 6(4): 162-167.
- Oranusi SU, Dahunsi SO, Owoso OO, Olatile T (2013) Microbial Profile of Hands, Food, Easy Contact Surfaces and Food Surfaces: A Case Study in a University Campus. J Nov Inter Biotech & Biosci 2(1): 30-38.
- Lindberg E, Adlerberth B, Hesselmar R, Saalman I, Strannegared N, et al. (2004) A High Rate of Transfer of Staphylococcus aureus from Parental Skin to Infant Gut Flora. J Clin Microbiol 42(2): 530-534.
- Bright KR, Boone SA, Gerba CP (2010) Occurrence of Bacteria and Viruses on Elementary Classroom Surfaces and the Potential Role of Elementary Classroom Hygiene in the Spread of Infectious Diseases. J Sch Nurs 26(1): 33-41.
- Nworie A, Ayeni JA, Eze UA, Azi SO (2012) Bacterial Contamination of Door Handles/Knobs in Selected Public Conveniences in Abuja Metropolis, Nigeria; a Public Health Threat. Continental J Med Res 6(1): 7-11.
- Chinakwe EC, Nwogwugwu NU, Nwachukwu IN, Okorondu SI, Onyemekara NN, et al. (2012) Microbial Quality and Public Health Implication of Hand-Wash Water Samples of Public Adults in Owerri, South-East Nigeria. Inter Res J Microbiol 3(4): 144-146.
- Lambrechts A, Human IS, Doughari JH, Lues JFR (2014) Bacterial Contamination of the Hands of Food Handlers as Indicator of Hand Washing Efficacy in Some Convenient Food Industries in South Africa. Pak J Med Sci 30 (4): 755-758.
- Reynolds KA (2005) Hygiene of Environmental Surfaces. International Journal of Environmental Health Research June 2005 15(3): 225-234.
- Li S, Eisberg J, Sicknall I, Koopman J (2009) Dynamics and Control of Infections Transmitted from Person to Person Through the Environment, Am J Epidemiology 170(2): 257-265.
- Salim B, Nura S, Ifanifa M (2016) Isolation and Identification of Bacterial Contaminants from Door Handles of Public Toilets in Federal University Dutse, Jigawa State-Nigeria. ISOR Journal of Pharmacy and Biological Sciences 11(5): 53-57.
- Lynn M, Vivian A, Wasa A (2013) The Prevalence of Bacterial Organisms on Toilet Door Handles in Secondary Schools in Bokkos LG.., Jos, Plateau State, Nigeria. ISOR Journal of Pharmacy and Biological Sciences 8(4): 85-91.
- Amala E, Ade J, Bloomfield F (2015) Bacteria Associated with Toilets and Offices Lock Handles. International Journal of Epidemiology and Infectio 3(1): 12-15.
- Monarca S, Grottolo M, Renzi D, Paganelli P, S Zerbini I, et al. (2000) Evaluation of Environmental Bacterial Contamination and Procedures to Control Cross Infection in a Sample of Italian Dental Surgeries. Occupational and Environmental Medicine 57(11): 721-726.
- Otter J, French G (2009) Bacterial Contamination on Touch Surfaces in the Public Transport System and in Public Areas of a Hospital in London. Letters in Applied Microbiology 49(6): 803-805.
- Kennedy DI, Enriquez CE, Gerba CP (2005) Enteric Bacterial Contamination of Public Restrooms.
- Mensha O, Okeke A, Oyewole O, Osopale A (2016) Isolation of Bacterial Pathogens from Selected Door Handles in a Southwestern University in Nigeria. Acta Satech 7(1): 1-5.
- Brooks F, Carrol C, Butel S, Jawetz A (2007) Medical microbiology, (24th) McGraw-Hill publishers: New York, USA.
- Samy A, Hamdy E, Rusin P (2012) Pathogenic Bacteria Associated with Different Public Environmental Sites. Journal of Medical Microbiology 2: 133-137.

We use cookies to ensure you get the best experience on our website.